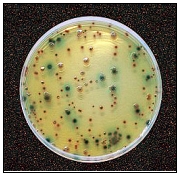
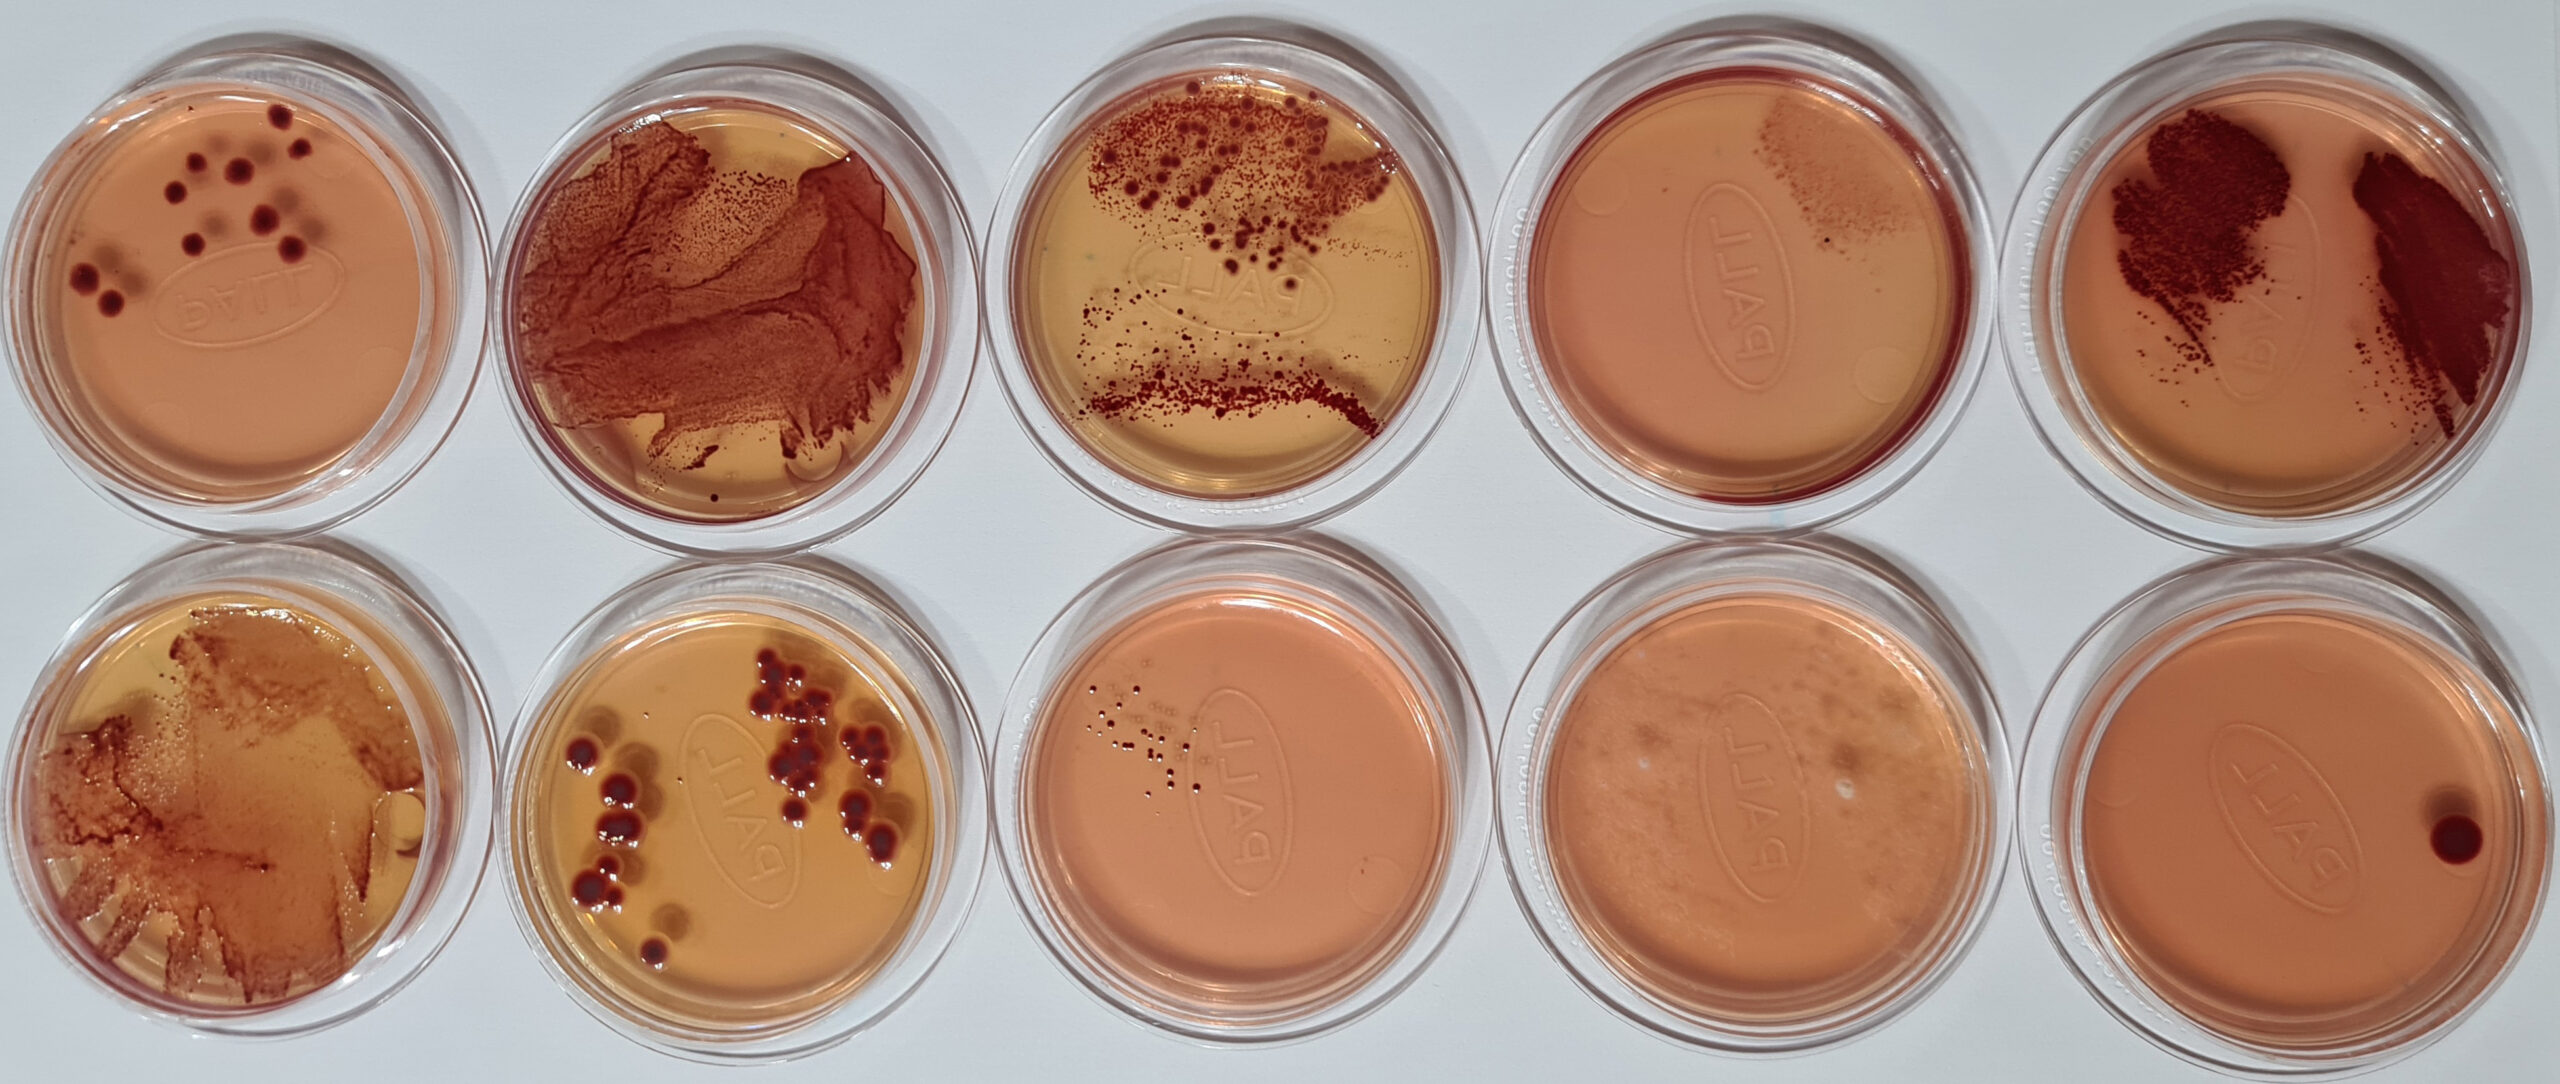

Medios de cultivo para microbiología: los medios más interesantes de MICROKIT, tanto clásicos (bioquímicos) como cromogénicos (enzimáticos)
Medios de cultivo para microbiología
Los medios de cultivo son el método de referencia para detectar y enumerar microorganismos en alimentos, aguas, bebidas, medicamentos, cosméticos, ambientes…
Además son el método más robusto: válido para todo tipo de muestras y situaciones.
Y son el método que tiene más experiencia acumulada en los laboratorios de todo el mundo, a diferencia de los métodos indirectos, que buscan indicios, en vez de buscar el microorganismo en concreto.
Medios de cultivo para microbiología clásicos
Los medios clásicos tienen más de 1 siglo de antigüedad, se basan en la bioquímica/fisiología de los microorganismos, por lo que suelen obtener una media del 30% de resultados falsamente positivos (en el caso de medios selectivos).
Medios de cultivo para microbiología cromogénicos
Los medios cromogénicos tienen apenas 3 décadas de antigüedad, son mucho más específicos porque se basan en pruebas enzimáticas, por lo que la media de falsos positivos en medios selectivos/diferenciales se reduce drásticamente al 0,1-5%.
En los caldos (Broth)
se enriquece, multiplicando la población inicial hasta niveles detectables (turbidez y cambio de pH en los clásicos, cambio de color específico en los cromogénicos).
Y en los agares (medios sólidos)
se aíslan los microorganismos, multiplicándose cada uno (ufc) hasta formar colonias visibles a simple vista, gracias a la incubación en estufas a 21-44ºC, en general.
En los caldos clásicos,
aparte de la turbidez, puede haber cambios de color muy poco específicos, debidos al cambio de pH que provoca la proliferación de los microorganismos presentes, sean o no el buscado o «diana».
Y en los caldos cromogénicos,
aparte de la turbidez, hay cambios de color específicos debidos a la reacción enzimática específica del microorganismo buscado o «diana».
En los agares clásicos,
las colonias tienen colores especiales y a menudo el medio vira por cambios de pH.
Y en los agares cromogénicos,
las colonias tienen colores muy específicos y el medio no vira de color por los cambios de pH que provoca el crecimiento microbiano.
A menudo hace falta un caldo, seguido de un agar, para detectar un microorganismo concreto. Para recuentos se emplea directamente un agar sin pasar antes por el enriquecimiento en caldo (aunque se use un caldo común para convertir las muestras sólidas o densas en líquidas).
Para distinguir los agares del agar-agar (como ingrediente solidificante de los medios sólidos), el agar-agar no se llama sólo «agar», sino «agar-agar». A menudo la versión agar de un medio es simplemente el caldo (Broth) con agar-agar.
Los medios MICROKIT más recomendables, según el tipo de muestra o «matriz» son:
1-Medios de cultivo para microbiología de ALIMENTOS
BUFFERED PEPTONE NEUTRALIZING WATER
A diferencia del agua de Peptona Tamponada clásica, este medio patentado por MICROKIT neutraliza los conservantes y especias del alimento, además de los metabolitos de la microbiota acompañante, por lo que partiendo de él, todo funciona mucho mejor.
El efecto matriz queda así ámpliamente combatido
CROMOKIT® RAPID PCA CROMOGÉNICO
El PCA cromogénico de MICROKIT, uno de los medios cromogénicos más económicos que existen, permite ver las colonias (rojas) en mayor contraste con el medio.
Eso hace que se vean antes, más (también las colonias diminutas que no se distinguen en PCA clásico) y sin los artefactos (burbujas, partículas de muestra…) que provocan falsos positivos en PCA clásico.
Y así la vista del analista tardará muchos más años en desgastarse, al no tener que forzarla en los recuentos.
El único proveedor que ofrece este medio, tanto en versión deshidratada termoerstable, como en todo tipo de medios preparados.
.
RAPID SABOURAUD RYM AGAR
Los medios clásicos para recuento de hongos (levaduras + mohos) suelen tardar 3-5 días en obtener resultados.
Mediante el RYM Agar de MICROKIT obtendrá los recuentos de hongos en sólo 36-48 horas. Además, desde las primeras 18 h, este medio ya anuncia la presencia de hongos, por el viraje que presenta de violeta a amarillo antes de que aparezcan las colonias.
.
CROMOKIT® MUG PLUS CROMOG. AGAR
Este medio, ya normalizado ISO en aguas, permite el recuento de E.coli (colonias azules) y demás coliformes (colonias rosas) también con resultados excelentes en alimentos, con resultados mucho más exactos que el TBX para E.coli o que el VRBL para coliformes. Y encima en un solo medio.
Las colonias crema, amarillas, verdes o de otros colores, no son ni de E.coli ni de otros
coliformes, por lo que, si aparecen, no se cuentan ni se investigan.
La gama de azules (desde el turquesa hasta el violeta) significa E.coli.
La gama de rosas (desde el rosa tenue hasta el fucsia e incluso púrpura) significa Coliforme.
SALMONELLA-SHIGELLA BROTH
A diferencia del Selenito (medio muy tóxico para el analista) y del Rappaport (medio con falsos negativos en ciertas cepas de Salmonella y en todas las de Shigella), SS Broth de MICROKIT permite la detección de todas las Salmonella spp y Shigella spp sin riesgos para el analista que lo prepara.
El mejor medio de enriquecimiento selectivo para Salmonella y para Shigella.
CROMOSALM ABC ISO 6579 AGAR
Otro medio de MICROKIT que entra en la ultima versión de la Norma ISO 6579, bajo el nombre de ABC Agar.
A diferencia de todos los medios magenta-Gal, en Cromosalm ABC las colonias de Salmonella spp son verde-azuladas, las de Citrobacter spp y E.coli son negras y las de Proteus spp son incoloras, por lo que estos acompañantes no interfieren ni provocan falsos negativos como ocurre en los otros medios.
CHROMOCYTOGENES AGAR O&A ISO 11290
El medio cromogénico que acabó hace ya 20 años con los problemas de detección que sufría Listeria monocytogenes con medios clásicos: colonias cóncavas, verdes, con halo (y que son Rhamnosa+ y Xylosa-, kit M-Ident R/X)
2-Medios de cultivo para microbiología de AGUAS y BEBIDAS
YEAST EXTRACT AGAR ISO 6222
El medio obligado por Directiva UE en aguas para recuento de aerobios oligotrofos (por su ausencia de glucosa), también llamado PCA-water o PCA sin azúcares.
En MICROKIT ofrecemos, además, la versión cromogénica termoestable, para que las colonias (rojas) se vean mejor en contraste con el color crema blanquecino del medio (si se siembra 1 mL de agua en masa) o con el color blanco de la membrana (si se filtran volúmenes mayores de agua).
COLÍFAGOS SCHOLTEN AGAR ISO 10705-2
Disponible en MICROKIT desde que salió en Norma ISO (año 2010) en todas sus versiones: deshidratado, placas preparadas, frascos para fundir y hacerse placas… ya obligado por Directiva Europea en aguas de consumo humano desde Enero 2023. Se siembra la muestra mezclando el medio con E.coli y se cuentan las calvas de lisis provocadas por los virus bacteriófagos en esta bacteria (de ahí el nombre de colífagos):
Tambien disponibles en MICROKIT los medios de la otra parte de dicha Norma (ISO 10705-1)(Bacteriófagos ARN-F específicos)
CROMOKIT® MUG PLUS CCA AGAR ISO 9308-1
El primer medio cromogénico aprobado en Norma ISO, ahora de obligado cumplimiento según Directiva UE de aguas de consumo humano.
Permite la detección y el recuento de E.coli (colonias azules) y demás coliformes (colonias rosas).
Las colonias crema, amarillas, verdes o de otros colores, no son ni de E.coli ni de otros coliformes, por lo que, si aparecen, no se cuentan ni se investigan.
La gama de azules (desde el turquesa hasta el violeta) significa E.coli.
La gama de rosas (desde el rosa tenue hasta el fucsia e incluso púrpura) significa Coliforme.
En este el medio de MICROKIT se puede confirmar directamente en las colonias, en segundos, tanto la oxidasa (- en colonias rosas de coliformes) como el Indol (+ en colonias azules de E.coli)
.
CETRIMIDA CN RAPID AGAR CROMOGÉNICO
El medio ISO 16266 con un cromógeno que permite ver las colonias (rojas) mucho antes (18-24 h en vez de 48 h). Sólo en las muestras que den positivo, hay que seguir incubando otras 18-24h (tiempo total final: igual al del medio clásico) para ver si son fluorescentes, propias de Ps.aeruginosa
.
RAPID BILIS ESCULINA AZIDA ISO 7899
Según la ISO 7899, por este parámetro de Enterococos fecales hay que retrasar un día los resultados del agua de consumo humano, pasando la membrana primero por Slanetz-Bartley 48 h y luego por BEA otras 4 h, lo cual nos parece aberrante cuando los otros dos indicadores (E.coli-Coliformes y Clostridium perfringens) permiten conocer el estado del agua en sólo 24 h. Y porque en MICROKIT hemos validado nuestro medio BEA para uso directo de la membrana sin paso previo por Slantez-Bartley. Los resultados son idénticos por el método ISO 52h que por el método MICROKIT 18 h, sin falsos positivos ni falsos negativos, por lo que hemos rebautizado nuestro BEA como «Rapid BEA».
.
WL NUTRIENT BROTH
El recuento de bacterias y levaduras alterativas en bebidas alcohólicas (vino, cerveza…) se realiza con este fantástico medio y plaquitas de filtración con cartón absorbente. En MICROKIT ofrecemos este medio no sólo en versión deshidratada, sino también en preparado: ampollas 2 mL y viales pinchables supereconómicos 100 mL para 50 test.
3-Medios de cultivo para microbiología de MEDICAMENTOS
TIOGLICOLATO FTM
El medio Farmacopea para control de esterilidad de aerobios, anaerobios y microaerófilos.
Su turbidez intrínseca se ve incrementada por el crecimiento de cualquier bacteria, lo cual indica que hay un problema en la esterilidad del lote del medicamento.
En MICROKIT lo ofrecemos deshidratado-granulado, y tambien preparado en frascos pinchables de 100 mL y en botellas de boca ancha (para poder meter en ellas medicamentos sólidos con menor necesidad de puntería).
TSB (TRYPTIC SOY BROTH) Y MEDIA FILLS
El otro medio Farmacopea para demostrar la esterilidad, en este caso de hongos y de aerobios.
En MICROKIT lo ofrecemos deshidratado-granulado (o en polvo), y tambien preparado en frascos pinchables de 100 mL y en botellas de boca ancha (para poder meter en ellas medicamentos sólidos con menor necesidad de puntería).
También ofrecemos el deshidratado en polvo, irradiado por rayos gamma (polvo estéril en las presentaciones adaptadas a cada laboratorio farmacéutico) para realizar el test de esterilidad del proceso: Media Fills for Validation of Aseptic Preparations (FDA)
TSA (TRYPTIC SOY AGAR)
El medio más empleado en industria farmacéutica para recuento y detección de aerobios, es también el medio elegido por la Norma ISO 11133-2 de control de calidad de medios de cultivo, como medio de referencia en los recuentos de cepas cuantitativas.
Lo ofrecemos en deshidratados (granulado o polvo) y en preparado: placas, Rodac, y tubos/ frascos para fundir y hacerse placas. Tenga en stock nuestros tubos o frascos de 2 años de caducidad para poder seguir trabajando si le falla su proveedor de placas preparadas.
4-Medios de cultivo para microbiología de COSMÉTICOS
LPT NEUTRALIZING BROTH
El caldo que ha demostrado en 15 años de intercomparación, ser el que mejor neutraliza y recupera (tras enriquecimiento) en todo tipo de cosméticos con todo tipo de conservantes.
Además es el único que en su formulación incluye agentes dopping para hongos (levaduras y mohos) y no se centra sólo en optimizar la detección y recuento de bacterias.
En su folleto encontrará además información precisa y demostrada sobre los tiempos óptimos de enriquecimiento (48 h) para que no se le escape ninguno de los patógenos que provocan retiradas de mercado de cosméticos por no cumplir con la legislación (aunque sus controles sigan las Normas ISO de microbiología cosmética).
Enriquecer menos tiempo es peligroso,
por no haber permitido a Candida albicans, a Staphylococcus aureus y a Burkholderia cepacia llegar a un nivel que sea detectable en la estría tras enriquecimiento.
Pero enriquecer más tiempo también es peligroso.
porque Pseudomonas aeruginosa, E.coli y Staphylococcus aureus pierden su viabilidad y no se manifiestan al estriarlos tras enriquecimientos más prolongados: entran en la fase degenerativa típica de la curva de crecimiento microbiano en un sistema cerrado, como son los medios de cultivo.
TSA MAXIM CROMOKIT ® AGAR
Con este medio, base TSA pero con factor dopping y un cromógeno para aerobios, fruto del I+D de MICROKIT, podemos realizar el recuento total de aerobios en sólo 36 horas con total fiabilidad. MICROKIT lo ofrece en deshidratado y en todo tipo de medios preparados. El contraste del color de las colonias (rojas) sobre el medio (crema blanquecino) permite detectar antes y más (colonias pequeñas) y cuidar la vista del analista.
.
RAPID SABOURAUD RYM AGAR
Los medios clásicos para recuento de hongos (levaduras + mohos) suelen tardar 3-5 días en obtener resultados.
Mediante el RYM Agar de MICROKIT obtendrá los recuentos de ambos grupos de hongos en sólo 36-48 horas. Además, desde las primeras 18 h, este medio ya anuncia la presencia de hongos, por el viraje que presenta de violeta a amarillo antes de que aparezcan las colonias.
CROMOKIT® MUG PLUS CROMOG. AGAR
Este medio, ya normalizado ISO en aguas, permite el recuento de E.coli (colonias azules) y demás coliformes (colonias rosas) también con resultados excelentes en cosméticos, con resultados mucho más exactos que el MacConkey Agar o el EMB Levine.
Y con efectividad demostrada ante el segundo patógeno emergente más frecuente en retiradas de mercado de cosméticos (tras Burkholderia cepacia): Pluralibacter gergoviae
Las colonias crema, amarillas, verdes o de otros colores, no son ni de E.coli ni de otros
coliformes, por lo que, si aparecen, no se investigan.
La gama de azules (desde el turquesa hasta el violeta) significa E.coli.
La gama de rosas (desde el rosa tenue hasta el fucsia e incluso púrpura) significa Coliforme.
CUP12 AGAR
Cuando estudiamos el número de cepas patógenas que provocan recurrentes retiradas de mercado de cosméticos por parte de las autoridades sanitarias (no sólo de España), nos asustamos: 14 microorganismos.
Luego pensando, lo vimos lógico, dada la contradicción entre lo que pide la legislación en su Reglamento UE (inocuidad y seguridad mediante un método de análisis validado -sea o no el ISO-) y el deficiente número de Normas ISO de microbiología cosmética que existen (sólo 4).
Pero sabíamos que nadie iba a incorporar 10 medios más en sus análisis, así que emprendimos el «imposible» reto de conseguir un medio que detectase el máximo número de estos 14 patógenos, pero dando el mínimo número de falsos positivos.
Y lo que conseguimos fué pura magia: el CUP12A, medio MICROKIT capaz de detectar 12 de esos 14 patógenos sin obtener falsos positivos que hicieran perder el tiempo en confirmaciones para que luego la colonia fuese de un inocuo.
Combinando este medio con el de Candida albicans y el de Staphylococcus aureus (los 2 de los 14 patógenos cosméticos que no «pesca»), no sólo no aumentamos el número de medios que deben emplearse en microbiología cosmética, sino que encima lo reducimos. Y en vez de 4 patógenos con 4 medios (o 5 patógenos con 5 medios si incluimos la Burkholderia cepacia) conseguimos detectar 14 patógenos con sólo 3 medios.
Para los más conservadores, detectamos los 14 patógenos con 5 medios (los 4 que usaban y CUP12A).
5-Medios de cultivo para microbiología AMBIENTAL (Superficies y Aire)
LPT/TSA NEUTRALIZING AGAR (Sea Incoloro, sea PURPLE)
El medio ISO 100.012 de recuento de aerobios en ambientes interiores también fué diseñado por MICROKIT hace ya 3 décadas. Ellos lo llamaron «LPT Neutralizing Agar Lilac» en vez de «Purple», pero es ese medio. Puede usarlo con púrpura o sin ella (la fórmula del resto del medio es la misma). Lo ofrecemos en deshidratado y en todo tipo de preparados, incluidas las placas Rodac.
.
ROSA BENGALA CAF AGAR
El medio para recuento de hongos en ambientes interiores también fué elegido en la ISO 100.012 en base a nuestros estudios publicados anteriormente a la misma: El Rosa Bengala Cloranfenicol Agar, por ser el que mejores resultados obtiene (recuento, diversidad de cepas y facilidad de recuento, al no invadir las colonias rápidas a las lentas). También lo ofrecemos en deshidratado y en todo tipo de preparados, incluidas las placas Rodac.
Ver también la entrada sobre test complementarios para microbiología:
https://www.medioscultivo.com/test-de-microbiologia/
Haga sus consultas de medios de cultivo en: microkit@microkit.es
Solicite asesoría técnica de expertos sobre qué medios funcionan mejor en sus muestras (según los resultados de 2 décadas de servicios intercomparativos) en: consultastecnicas@microkit.es
Solicite los precios actualizados en microkit@microkit.es
Si tiene dudas técnicas contacte con consultastecnicas@microkit.es
Haga sus pedidos en pedidos@microkit.es